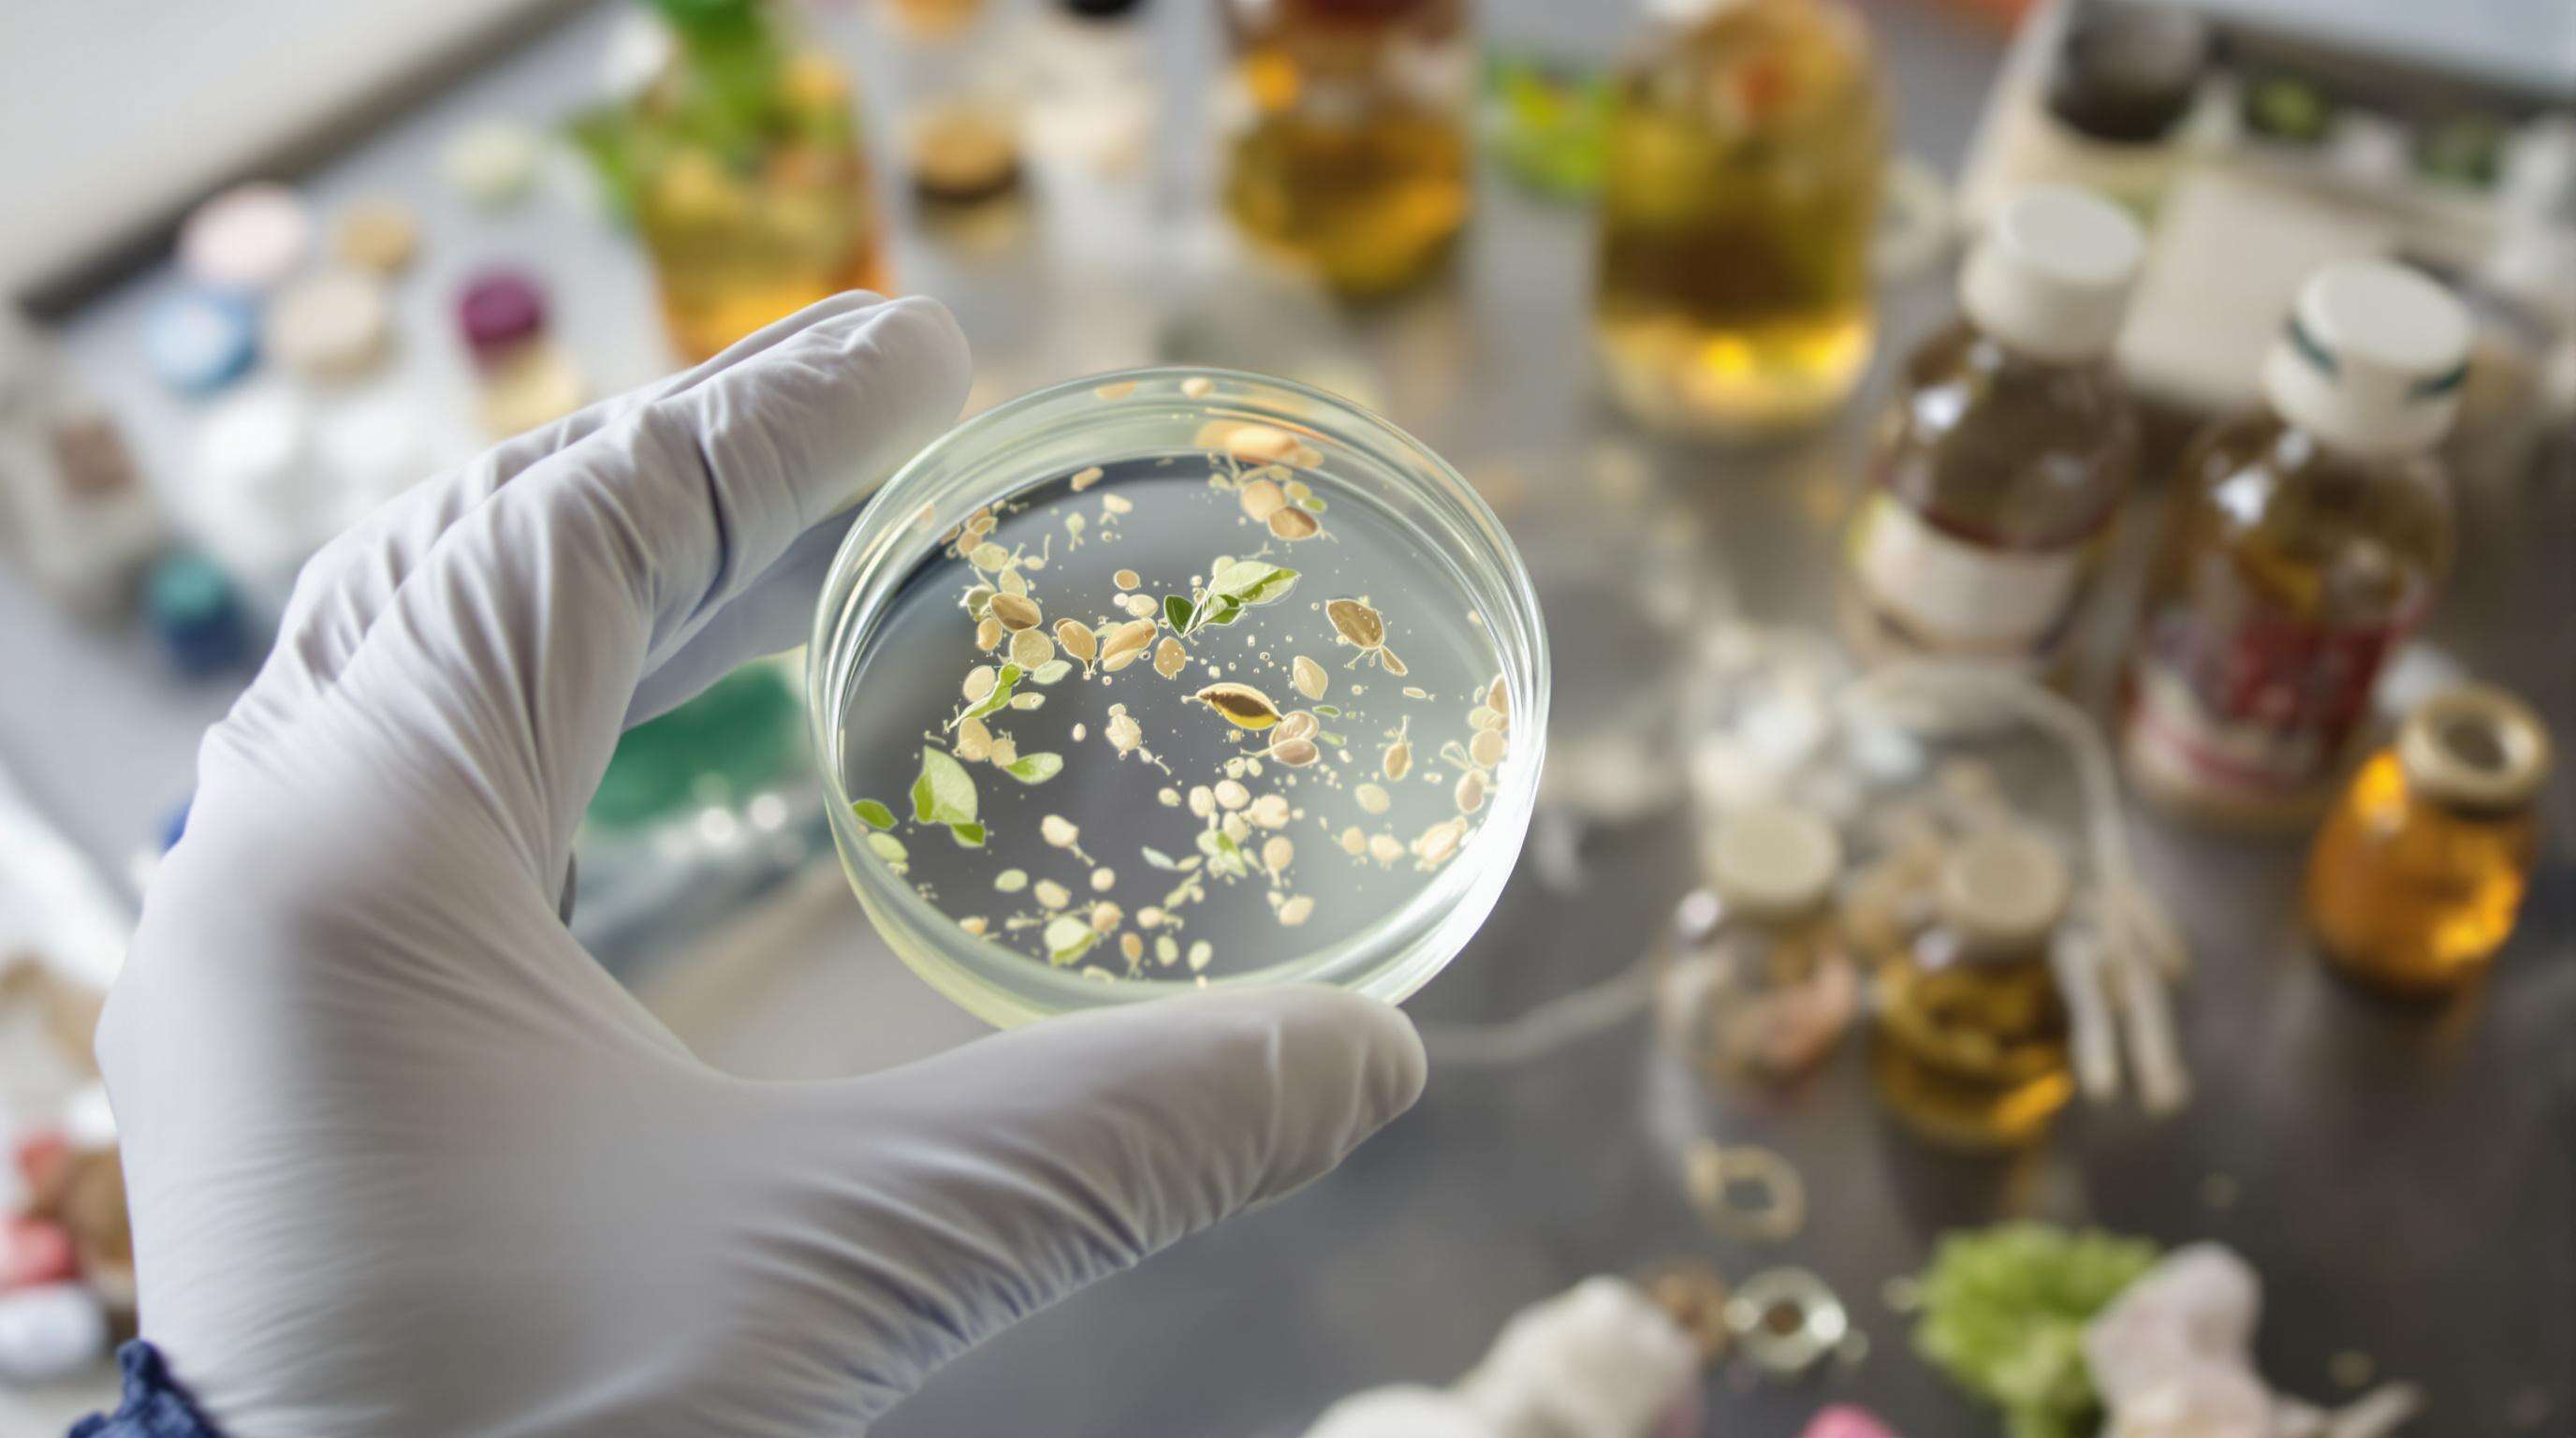
A gloved hand examining a botanical sample in a modern skincare lab, emphasizing innovation and ingredient transparency.

The beauty industry has always been dynamic, adapting to changing consumer preferences, technological innovations, and cultural trends. In recent years, one trend has stood out as a game-changer: the rising demand for luxury private label cosmetics. Discerning customers are no longer satisfied with mass-market products—they want unique, high-quality, and exclusive items that align with their lifestyle and values. At Joyocosmetic, we have been at the forefront of this movement, providing brands and entrepreneurs with the tools to create premium cosmetics that embody both luxury and individuality.
Private label cosmetics are products manufactured by one company but branded and marketed under another company’s name. While this model has existed for decades, its luxury segment has recently gained traction. Luxury private label cosmetics combine high-end formulations, premium packaging, and an elevated brand identity. They give businesses the opportunity to launch their own prestige beauty lines without building manufacturing capabilities from scratch. With Joyocosmetic, clients can choose from an extensive range of products—from silk-smooth face powders and richly pigmented lipsticks to professional-grade eye makeup and skin-friendly foundations—each customizable to reflect their unique brand image.
Today’s beauty consumers crave products that feel personal and exclusive. Luxury private label cosmetics allow brands to cater to specific niches, creating collections that reflect the preferences, skin tones, and lifestyles of their target market.
The digital age has lowered barriers for launching beauty brands. Social media platforms like Instagram, TikTok, and YouTube allow entrepreneurs to showcase products directly to consumers. With Joyocosmetic’s private label solutions, small and mid-sized businesses can offer luxury-level products that rival established global brands.
More consumers are willing to invest in beauty products that deliver visible results and provide a premium user experience. Luxury private label cosmetics meet these expectations with superior formulations, skin-safe ingredients, and elegant presentation.
The luxury beauty customer is increasingly conscious of sustainability. Joyocosmetic’s private label line emphasizes eco-friendly packaging, cruelty-free testing, and responsibly sourced ingredients—helping brands align with the values of environmentally aware shoppers.
High-Performance Formulations – Designed to deliver excellent coverage, long wear, and skin-enhancing benefits.
Premium Packaging – Sleek, sophisticated designs that reflect elegance and exclusivity.
Custom Branding – From logos to color schemes, every detail can be tailored to represent your identity.
Quality Control – Products go through rigorous testing to ensure safety, consistency, and performance.
Trend Responsiveness – Ability to launch products aligned with the latest beauty trends quickly.
At Joyocosmetic, we don’t just supply cosmetics—we partner with you to create a brand that tells a story. Our team offers comprehensive services that go beyond manufacturing:
Product Development – Work with experts to choose the right shades, textures, and finishes for your market.
Brand Consultation – Guidance on positioning your products for a luxury audience.
Packaging Design – Elegant, on-trend designs that appeal to premium customers.
Regulatory Compliance – Ensuring your products meet safety standards in all target markets.
By combining cutting-edge production with personalized service, Joyocosmetic ensures your private label cosmetics stand out in a competitive market.
Recent industry reports show that the global beauty market is expected to exceed $700 billion by 2028, with the premium segment leading growth. Luxury private label cosmetics are predicted to gain a significant share as more brands leverage this model to differentiate themselves.
A major factor in this growth is consumer trust in boutique and influencer-led brands. Shoppers are drawn to the authenticity, relatability, and niche expertise of smaller luxury labels—a demand that Joyocosmetic is uniquely positioned to meet.
Face Makeup – Ultra-lightweight foundations, hydrating concealers, and silk-finish powders.
Eye Makeup – Rich eyeshadow palettes, waterproof eyeliners, and volumizing mascaras.
Lip Makeup – Long-lasting matte lipsticks, moisturizing glosses, and lip tints.
Makeup Accessories – Premium brushes, beauty sponges, and compact mirrors.
All of these categories are available in our Joyocosmetic portfolio, customizable to match your brand’s aesthetic and market needs.
Define Your Niche – Focus on a specific audience, such as clean beauty enthusiasts, high-fashion makeup lovers, or vegan cosmetics fans.
Prioritize Quality – Luxury consumers expect superior performance—choose formulations that deliver on promises.
Invest in Branding – Create a strong visual identity and storytelling strategy to connect with your audience.
Leverage Marketing Channels – Use social media, influencer partnerships, and targeted ads to build awareness.
Stay Ahead of Trends – Regularly refresh your product line with innovative textures, shades, and formulas.
The growing demand for luxury private label cosmetics reflects a fundamental shift in how consumers engage with beauty. People want more than products—they want experiences, authenticity, and a sense of belonging. With Joyocosmetic’s expertise, premium formulations, and end-to-end support, your brand can meet these expectations and thrive in the competitive beauty landscape. Whether you’re an established retailer looking to expand into luxury cosmetics or a new entrepreneur ready to launch your first collection, Joyocosmetic offers the resources, creativity, and quality to turn your vision into a world-class beauty brand.